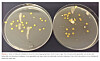

FAG Originalartikkel
Metylering av genomisk DNA hos monocytter og makrofager
Av LEON N. STELLANDER, MIKKEL TOLLEFSEN og IDA AAGÅRD
Metylering av genomisk DNA hos monocytter og makrofager.pdf(374 KB)
Vaksinasjon er et av de største fremskrittene innen moderne helse (1). Sykdommer og epidemier har blitt helt eller delvis utryddet, og vaksinasjon redder millioner av menneskeliv hvert år. Vaksiners virkning skyldes immunforsvarets normale respons mot fremmede agens, men som regel tilsettes også adjuvans for å forsterke effekten av vaksinen. Oftest brukes aluminiumsalter som adjuvans (Al-adjuvans) (2). De konkrete virkningene av slik adjuvans på cellenivå er lite undersøkt og det er behov for mer kunnskap (3, 4).
Monocytter og makrofager utgjør en viktig del av immuncellene i medfødt immunitet og har en generell, initierende immunrespons mot mikrobestrukturer og frigjorte intracellulære molekyler fra skadede og ødelagte celler (5). Monocytter befinner seg i utgangspunktet i blodbanen, men kan etablere seg i vev og differensiere til vevsspesifikke makrofager, for eksempel ved en infeksjon (6). Andre makrofager er vevsbundne fra tidlig i fosterlivet (7). Makrofager er blant de første cellene som responderer på en infeksjon eller vaksineinjeksjon. De opptrer som antigenpresenterende celler (APC) og presenterer mikrobe- eller vaksine-antigener for T-lymfocytter. Slik stimulerer de det ervervede immunforsvaret, med blant annet antistoffproduksjon som resultat. Både B- og T-lymfocytter i ervervet immunforsvar kan bli hukommelsesceller etter andregangs infeksjon eller vaksinasjon, og er essensielle for å oppnå immunitet mot ulike sykdommer (8).
Påvirkning av ulike signalmolekyler, som cytokiner, kan gi makrofager spesialiserte egenskaper og funksjoner. Monocytter fra blodbanen kan isoleres og differensieres in vitro til ulike typer monocytt-deriverte makrofager, ved tilsetning av spesifikke cytokiner (figur 1). Disse cellene er svært plastiske og endrer både fenotype og funksjon basert på signaler fra sitt nærmiljø. Makrofagpopulasjonen består dermed av celler med mange svært ulike fenotyper og funksjoner (9).

Uspesifikke M0(null)-makrofager er hvilende celler uten noen spesifikk funksjon og dannes når monocytter utsettes for visse vekstfaktorer. Polarisering av uspesifikke M0-makrofager deles forenklet inn i to hovedgrupper, M1 og M2 (figur 1), men med et spekter av andre makrofagfenotyper mellom. M1-makrofagene er proinflammatoriske. De fagocytterer mikroorganismer og danner et toksisk, nedbrytende miljø for mikrobene. Deres oppgaver inkluderer utskillelse av proinflammatoriske signalmolekyler (cytokiner) som rekrutterer andre immunceller til infisert vev. De viktigste cytokinene som produseres og bidrar til å indusere immunresponser med dannelse av antistoffer, er IL-6, IL-12, IL-1β og TNF-α (10).
M2-makrofagene er anti-inflammatoriske. De bidrar aktivt i sårheling, angiogenese (dannelse av nye blodårer), fibrose, potent fagocytose av nedbrutte stoffer og celler, samt tumorprogresjon. M2-makrofagene skiller hovedsakelig ut Arginase-1, IL-10 og TGF-β samt andre anti-inflammatoriske cytokiner som demper immunresponser (10).
Overflatemarkører
Makrofagene har ulike overflatemarkører (Cluster of differentiation (CD)-markører) som uttrykkes i varierende mengde hos hver enkelt fenotype. Disse kan identifiseres med fluorokrommerkede antistoffer. CD14 er et overflateprotein som uttrykkes på de fleste makrofager og andre celler av myeloid opprinnelse. CD80 uttrykkes hovedsakelig på M1-makrofager, men kan ses i lave mengder hos M0- og M2-makrofager. CD206 uttrykkes på de fleste makrofager, men i høyere konsentrasjon på M2-makrofager (11, 12).
DNA-metylering
DNA i alle celler hos et individ er identisk, men genuttrykket reguleres ulikt og definerer hva slags vev og funksjon cellen representerer. Regulering av genuttrykk foregår på flere nivåer, blant annet i form av binding av metylgrupper (CH3) til DNA. Metylgruppen fester seg til C5-posisjonen på cytosinets ringstruktur, spesifikt der cytosin er bundet med guanin (CpG-setet). Bindingen danner 5-methylcytosin (5mC) som kan detekteres med monoklonale antistoffer i ELISA-analyser. Når DNA metyleres, nedreguleres transkripsjonsmulighetene. Proteiner som binder metylert DNA bidrar også til inaktivering av nærliggende gener og hemmer transkripsjonen (13, 14). Ifølge Moore et al. (14) er metyleringen essensiell for blant annet inaktivering av retrovirale komponenter og regulering av vevsspesifikke genuttrykk.
Denne studien har undersøkt om metylering i cellenes DNA endres ved monocyttenes differensiering in vitro til uspesifikke makrofager – M0 (null), og ved videre in vitro polarisering til monocyttderiverte M1- og M2-makrofager. Resultatene kan bidra til å danne grunnlag for videre studier av den mulige effekten Al-adjuvans har på metylering av DNA i de samme prosessene.
Materiale og metode
Prøvemateriale
Vi benyttet leukocyttkonsentrat (buffycoat) fra fem friske blodgivere for isolering av monocytter fra perifert blod. Buffycoat er restproduktet etter separasjon av erytrocytter og plasma fra fullblod, og inneholder for det meste blodplater og store mengder leukocytter.
Isolering av monocytter
Vi isolerte først leukocytter fra buffycoat med Ficoll gradientmedium (Ficoll-Paque PLUS, VWR, art.nr 17-1440-03) i henhold til protokoll (15). For å vurdere andelen monocytter blant leukocyttene analyserte vi isolatet flowcytometrisk på BD Accuri C6TM (BD Biosciences, USA, kat.nr C6), (16). Vi brukte så en magnetisk separasjonsteknikk, «Magnetic-activated cell-sorting (MACS)» (Classical Monocyte Isolation Kit, human (MACS Isolerings-kit, Miltenyi Biotec, kat nr 130-117-337), til negativ seleksjon av klassiske, humane CD14+CD16- monocytter fra Ficoll-separeringen, som beskrevet i protokollen (17).
Differensiering og polarisering
Etter isoleringen aktiverte vi først monocyttene in vitro med makrofag-kolonistimulerende faktor (Macrophage Colony-Stimulating Factor, M-CSF (Miltenyi Biotec, kat.nr 130-096-491) tilsatt serumfritt vekstmedium (SFM, ThermoFischer, kat.nr 12065074). Cellene dyrket vi i 6-brønners celledyrkningsplater (6 wells, surface treated sterile Tissue Culture Plates, VWR, kat.nr 10062-892). For videre differensiering og polarisering av monocyttene benyttet vi et utvalg av cytokiner tilsatt vekstmediet før vi høstet cellene for DNA-ekstraksjon.
Differensiering- og polariseringsforsøkene foregikk i følgende trinn:
Dag 0:
Monocyttene fortynnet vi til 1x 106 celler/mL med SFM før utsåing i 6-brønners plater og inkuberte dem i 2 timer ved 37°C for adhesjon. Vi fjernet så mediet forsiktig og tilsatte SFM med 20 ng/mL M-CSF.
Celler fra to av brønnene eluerte vi til metyleringsanalyse uten å tilsette M-CSF. Vi benyttet Accutase (Accutase – Enzyme Cell Detachment Medium, Invitrogen, kat.nr 00-4555-56) i to runder for å reversere adhesjon, før vi høstet cellene med celleskrapere (Cell scraper 25 cm, Sarstedt, kat.nr 83.3950). Vi eluerte cellene i DNA-buffer (Resuspension Solution, Sigma-Aldrich, kat.nr R1149) før nedfrysing i -20°C for DNA-ekstraksjon.
Dag 1:
Vi fjernet gammelt medium, tilsatte nytt SFM med 20 ng/mL M-CSF til resterende brønner med celler og inkuberte i 37°C i to dager for differensiering til M0-makrofager.
Dag 4:
Polarisering av M0-makrofager. Vi fjernet gammelt medium og tilsatte nytt SFM med 20 ng/mL M-CSF til brønner som representerte M0-makrofager (M0). Brønner til M1-makrofager fikk SFM med 20 ng/mL M-CSF, 20 ng/mL IFN-y (Miltenyi Biotec, kat.nr 130-096-873) og 20 ng/mL LPS (Sigma-Aldrich, kat.nr L2630). Brønner til M2-makrofager fikk SFM med 20 ng/mL M-CSF og 20 ng/mL IL-4 (Miltenyi Biotec, kat.nr 130-093-917). Så inkuberte vi i 37°C til dag 6.
Dag 6:
Cellepolariseringene klargjorde vi nå til konsentrasjonsbestemmelse av DNA. Vi fjernet mediet og vasket cellene med PBS (Gibco, kat.nr 10010023). Vi eluerte cellene med Accutase, suspenderte dem i DNA-buffer og oppbevarte dem i -20°C til DNA-ekstraksjon som beskrevet på dag 0.
Ulike monocytt- og makrofagpopulasjoner verifiserte vi med en kombinasjon av mikroskopi, flowcytometri og deteksjon av cytokinsekresjon til cellemediet. Celleadhesjon, vekst, differensiering og polarisering kontrollerte vi mikroskopisk med Olympus CKX41 (Olympus Life Sciences, Japan). Adherente og flytende celler er svært forskjellige og kan lett vurderes visuelt. Vi utførte alle analysene kun på adherente celler. Monocytter som ikke hadde festet seg til celledyrkningsplatene, vasket vi bort ved mediebytte.
Flowcytometri
Cellemengde, renhet og konsentrasjon av monocytter og makrofager dokumenterte vi med flowcytometri. Tilstedeværelsen av CD-markørene, og dermed celletypen, identifiserte vi slik;
M0-makrofager farget vi med isotypekontroll-antistoffer. M1-makrofager farget vi med FITC-anti-CD14 (Invitrogen, kat.nr MHCD1401) og APC-anti-CD80 (Miltenyi Biotec, kat.nr 130-122-938). M2-makrofagene farget vi med PE-anti-CD206 (BD Pharmingen, kat.nr 555954).
7AAD (7-Aminoactinomycin D) tilsatte vi for deteksjon av døde celler (Molecular Probes, kat.nr A1310) (18). 7AAD-fargingen brukte vi til å gate for levende celler, slik at døde celler med uspesifikk binding av antistoffer og mye autofluorescens i størst mulig grad ble ekskludert i analysene av bundne antistoffer mot CD-markørene (resultater ikke vist).
Cytokinverifisering
Vi oppbevarte cellemedium fra differensierte celler i – 20°C og benyttet sandwich-ELISA til verifisering av cytokinproduksjon hos de ulike makrofagpopulasjonene. Vi analyserte cellemediet for innhold av TNF- α og IL-10 med ELISA-kit (DuoSet ELISA (Human), R&D Systems, kat nr DY210 (TNF-α) og DY217B (IL-10), i henhold til protokoll. Vi brukte en negativ standard (R&D Diluent (Reagent Diluent Concentrate 2 (10X), kat.nr DY995) og syv seriefortynnede standarder (halveringsfortynninger i R&D Diluent) fra ELISA-kitene.
DNA-ekstraksjon
Vi ekstraherte DNA fra frosne celler resuspendert i DNA-buffer (Resuspension Solution, Sigma-Aldrich, kat.nr R1149, kat. nr) med Sigma-Aldrich GenElute Mammalian Genomic DNA Miniprep Kit, kat.nr G1N10) i henhold til protokoll. Til elueringen benyttet vi 200uL elueringsbuffer (Elution Solution (10 mM Tris-HCl, 0,5 mM EDTA, pH 9,0). Eluatene oppbevarte vi ved -20 C° før og etter konsentrasjonsbestemmelse.
Konsentrasjonsbestemmelse av DNA gjorde vi med Qubit 1x dsDNA HS Kit (Thermo Scientific, kat.nr Q33231). Vi målte DNA-mengde ved 485 og 530 nm (Spectramax iD3, Molecular Devices, VWR, kat.nr 735-0391).
ELISA metyleringsanalyse
Vi benyttet indirekte ELISA til måling av metyleringsmengden i makrofagpopulasjonene (19).
Vi fortynnet alle prøver til samme DNA-konsentrasjon. Prøven med lavest DNA-konsentrasjon bestemte konsentrasjonen for alle prøvene i serien, og ble begrensende faktor i analysen. Metylert kontroll-DNA på 50 ng/µL (Methylated Control DNA, Sigma-Aldrich, kat.nr M8570) fortynnet vi til høy (0,50 ng/uL), middels (0,25 ng/uL) og lav mengde (0,125 ng/uL) per brønn. Negativ kontroll var kun bindingsbuffer (DNA binding Microplate Solution, Abcam, kat.nr ab156917).
Brønnene ble coatet med prøvematerialet, deretter inkuberte vi med primærantistoff 1,0 mg/mL anti-5mC (Epigentek, art.nr A-1014-010) og siden med et konjugert sekundærantistoff 1,5 mg/mL HRP anti-mus-IgG (Epigentek, art.nr ASJ-TWM7HO-100) som kun binder primærantistoff hvis dette er bundet til prøvematerialet.
Statistiske tester
Vi analyserte endring i metyleringen fra monocytter til makrofager, og deretter fra M0-makrofager til M1- og M2-makrofager. Resultatene fra konsentrasjonsmålingene og metyleringsanalysene er gjennomsnittet av verdiene fra fem donorer. Vi utførte paret to-sidig T-test (Student’s T-test) for å sammenlikne resultatene mellom gruppene, der p < 0,05 ble vurdert som statistisk signifikant.
Resultater
Flowcytometri og mikroskopering
Flowcytometri bekreftet monocyttenes renhet etter isolering (figur 2) og at cellepopulasjonene var makrofager. M1-makrofagene bekreftes ved høyere uttrykk av CD80 enn M0- og M2-makrofagene. CD206 uttrykkes i alle tre cellepopulasjonene, men mest hos M2-makrofagene (figur 3). CD14 uttrykkes av alle tre populasjonene (ikke vist).


Verifisering av vellykket differensiering og polarisering ble gjort mikroskopisk. Figur 4 viser de morfologiske endringene i de tre ulike makrofagpopulasjonene etter henholdsvis aktivering, differensiering og polarisering.

Differensiering til M0-makrofager ses tydelig ved at cellene endres fra runde (inaktive) monocytter til avlange (aktive) makrofager. Ved polarisering til M1-makrofager observeres flere endringer. Cellene «strekker» seg ut og danner «nettverk» med andre makrofager. Hos M2-makrofagene ble hovedsakelig en annen, mer langstrakt fasong enn hos M0- makrofagene observert. Det var en del inaktive, runde celler også her.
Cytokinverifisering
Cellemediet fra alle makrofagtyper ble analysert for deteksjon av utskilt TNF-α og IL-10. TNF-α ble ikke detektert hos M0- og M2-makrofagene, kun hos M1-makrofagene hvor det ble målt 182,55 pg/mL. IL-10 var under deteksjonsgrensen hos alle tre makrofagtypene.
DNA-bestemmelse og metylering
Makrofag-DNA fra alle fem donorene ble brukt til metyleringsanalyse av differensiering og polarisering.
Resultatene viser en signifikant nedgang i gjennomsnittlig metylering ved overgang fra monocytter til uspesifikke, in vitro monocytt-deriverte M0-makrofager (p < 0,05) (figur 5). Ved polarisering fra uspesifikke M0-makrofager til M1- og M2-makrofager ble det ikke påvist signifikant endring i metylering (p > 0,05) (figur 6). Beregnede p-verdier fra paret tosidig T-test vises i figur 5 og 6.


Diskusjon og konklusjon
Hensikten med studien var å undersøke om total metyleringsmengde i monocytters DNA endrer seg ved aktivering, differensiering og polarisering til in vitro monocytt-deriverte makrofager.
Resultatene fra disse metyleringsforsøkene viste en signifikant nedgang i metylering ved differensiering fra monocytter til in vitro monocytt-deriverte, uspesifikke M0-makrofager, men ikke ved polarisering fra uspesifikke M0 til M1 – og M2-makrofager. Redusert gjennomsnittsmetylering hos monocytter under differensiering indikerer at total genaktivitet er økt, og kan sies å være et forventet funn hos en cellepopulasjon som er i stor endring. Måling kan bare si noe om total metyleringsstatus, ikke hvor mange gener som er involvert eller i hvilken grad de er opp- eller nedregulert.
Metyleringsanalysene gir heller ikke svar på hvilke gener som gjennomgår en metyleringsendring, eller hvor på det kromosomale DNAet det skjer en metylering eller demetylering. Analysen gir svar på om den totale endringen, Δ-metylering, på hele genomet øker eller synker.
Ved differensiering av monocytter til uspesifikke M0-makrofager mediert av M-CSF, konkluderer Wallner et al. (20) med at genene gjennomgår en stor nedgang i metylering, noe funnene i denne studien bekrefter. Nedgangen forekommer i gener som regulerer aktin-cytoskjelett og fagocytose, og innebærer noen kritiske morfologiske endringer for makrofagenes immunologiske rolle. Disse genetiske områdene er metylert i andre somatiske celler.
Metyleringsendring ved overgang fra M0- til M1- og M2-makrofager er lite undersøkt, og resultatene her viser en liten, men ikke statistisk signifikant økning i metyleringsmengden.
M0-makrofager regnes som uspesifikke, og kan av den grunn ha en lavere grad av metylering, med flere tilgjengelige gener. Cellene kan tenkes å være åpne for tildeling av rolle som pro-inflammatoriske eller anti-inflammatoriske makrofager. Når M0-makrofagene så blir stimulert med cytokiner som differensierer dem til enten M1- eller M2-makrofager, ses en økning i metyleringen. Denne metyleringsøkningen forårsaker en nedgang i total mengde uttrykte gener og kan tenkes å avgrense cellene til sine spesifikke roller.
Undersøkelsene av metyleringsendring ved differensiering og polarisering har i denne studien resultater fra kun fem donorer. Det er for få deltakere til å representere en populasjon, og derfor er det essensielt med mange flere donorer for et mer representativt resultat.
Verifiseringsanalysene er ikke like gode for alle makrofagtypene. ELISA for verifisering av cytokinproduksjon og flowcytometri for påvisning av fenotypespesifikke CD-markører på makrofagpopulasjonene er begge tester hvor de beste og mest spesifikke markørene er rettet mot M1-makrofager. Andre markører og antigener detektert i analysene er uspesifikke og mer rettet generelt mot makrofager. Det er derfor kun M1- og M2-populasjonene som med sikkerhet blir verifisert i denne studien.
Deteksjon av cytokinproduksjonen fra M0-, M1- og M2-makrofagene var tilfredsstillende for kun ett av cytokinene det ble testet for. TNF-α er et cytokin som hovedsakelig produseres av M1-makrofager, og TNF-α ble kun detektert hos denne makrofagtypen. M1-populasjonen ble kun delvis bekreftet av cytokinanalysen. IL-10 produksjon brukes som en spesifikk markør for M2-makrofager, selv om det også produseres av en rekke andre makrofager i lave konsentrasjoner. IL-10 ble kun påvist i veldig lave mengder, men under deteksjonsgrensen på 25-30 pg/ml, hos alle populasjonene. Disse resultatene burde vært verifisert.
Cytokinanalysene for M0- og M2-populasjonene er mer usikre, og det ble benyttet flere verifiseringsanalyser. Cellepopulasjonene kan inneholde andre makrofager som fenotypisk befinner seg mellom ytterpolene M1 og M2, eller celler som aldri ble polarisert. Dette er hverken bekreftet eller avkreftet, og resultater fra metyleringsanalysene må tolkes med dette tatt i betraktning.
Resultatene fra flowcytometri viser uttrykk av respektive CD-markører i forventede konsentrasjoner og bekrefter populasjonen med M1-makrofager med stor sannsynlighet. M2-populasjonen bekreftes på grunn av relativt høyt uttrykk av CD206. Det er få gode og spesifikke markører for M0- og M2-makrofager, og det er vanskelig å bekrefte disse cellepopulasjonene med god sikkerhet. Uttrykk av CD14 på alle populasjonene bekrefter myeloid opprinnelse og at det er monocytter og makrofager som er benyttet i forsøkene.
Cellene ble mikroskopert for å kontrollere viabilitet, og for overvåkning av morfologiske endringer ved differensiering og polarisering. Differensiering av cellene til M0-makrofager fra runde (inaktive) til avlange (aktive) celler indikerer at cellene reagerer på stimuli. Men tilstedeværelse av fortsatt runde celler er en indikasjon på at ikke alle cellene responderer likt på samme stimuli.
Det er vanskelig å skille M0- og M2-populasjonene og det er usikkert med bare denne undersøkelsen om det ble jobbet med ulike populasjoner av makrofager. Det ble observert morfologiske endringer i noen grad ved de ulike makrofagtypene, samt monocyttene, og spesielt hos M1-makrofagene, som allikevel tyder på ulike fenotyper.
Kombinert analyse av makrofagene med mikroskopering, cytokinanalyser og måling av CD-markører gir en sikrere verifisering av cellepopulasjonene.
Betydning av resultatene og videre forskning
Resultatene fra denne metyleringsstudien er et lite steg mot videre forskning på hvordan DNA hos uspesifikke M0-makrofager metyleres under differensieringsprosessen og hvilke spesifikke gener som blir metylert eller demetylert i denne sammenheng. Ved å få kunnskap om hvilke gener som inngår i differensierings- og immuniseringsprosessene kan man lære mer om mekanismer som er knyttet til bruk av Al-adjuvans i vaksineutvikling og dermed makrofagenes rolle i vaksinering. Vaksiner kan utvikles til å bli mer spesifikt rettet mot de påvirkede mekanismene i makrofagene, slik at unødvendige bivirkninger unngås og forbedring av Al-adjuvans og god immunitet oppnås. Undersøkelse av flere donorer og benyttelse av andre, egnede genetiske analyser, kan kanskje bidra til bedre og mer målrettede vaksiner, samt større forståelse av genregulering i makrofager.
Takk
Vi ønsker å takke professor Håkan Eriksson ved Malmö Universitet for veiledning i – og verdifull kunnskap om – teknikker som ELISA, cellekulturer, celleekstraksjon, DNA-ekstraksjon, flowcytometri og dagens vaksineforskning. Vi vil også takke Ravi Danielsson og Irene Mile for all hjelp vi har fått på laboratoriet, og for å bytte medium på cellekulturene våre. Til slutt vil vi takke alle unevnte bidragsytere til våre undersøkelser, deres hjelp og rådgivning er uvurderlig.